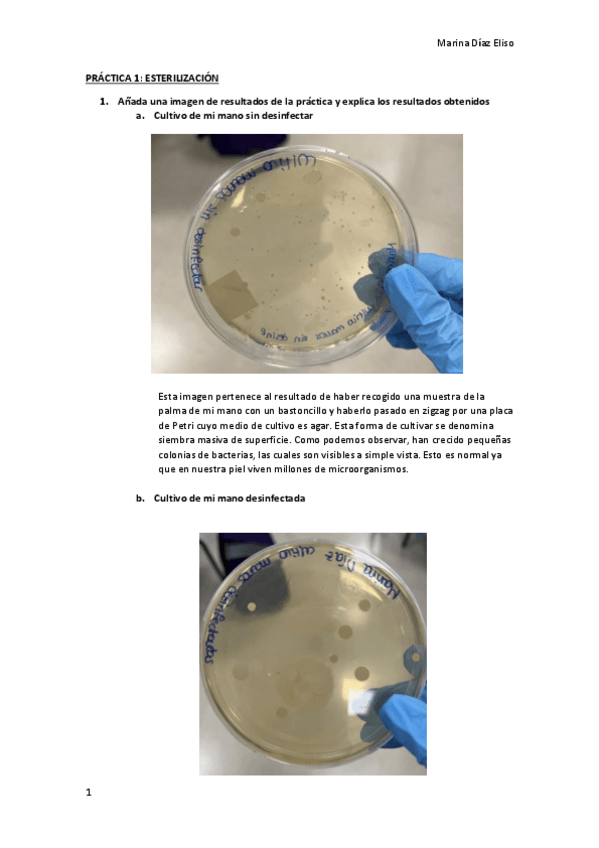

@idubeiuheiuh
23 Publicaciones
687 Interacciones
0 Seguidores
1 Siguiendo
Lista de publicaciones de idubeiuheiuh
He publicado nuevos practicas de 1º Química Orgánica: cuaderno-de-laboratorio.pdf
apuntes
-
Teoría y fórmulas
He publicado nuevos apuntes de 1º Estadística: Teoría y fórmulas
ejercicios
-
Relaciones de ejercicios
He publicado nuevos ejercicios de 1º Estadística: Relaciones de ejercicios
He publicado nuevos examenes de 1º Biología Celular: Examen-practicas-2023.pdf
He publicado nuevos practicas de 1º Biología Celular: Resumen-practicas.pdf
apuntes
-
Tema 1 Estadística Descriptiva
He publicado nuevos apuntes de 1º Estadística: Tema 1 Estadística Descriptiva
He publicado nuevos ejercicios de 1º Operaciones de Laboratorio Biotecnológico: Relacion-1-disoluciones-RESUELTA.pdf
He publicado nuevos apuntes de 1º Física: Formulas-campo-electromagnetico-tema-6.pdf
He publicado nuevos ejercicios de 1º Física: Relacion-ejercicios-tema-6-campo-electromagnetico.pdf
He publicado nuevos practicas de 1º Operaciones de Laboratorio Biotecnológico: Cuestiones-practicas-segunda-parte.pdf
He publicado nuevos apuntes de 1º FUNDAMENTOS DE INFORMÁTICA Y BIOINFORMÁTICA: APUNTES-BUCLES.pdf
He publicado nuevos practicas de 1º Física: PRACTICA-ARQUIMEDES-CORREGIDA.pdf
He publicado nuevos apuntes de 1º FUNDAMENTOS DE INFORMÁTICA Y BIOINFORMÁTICA: Tests-y-tarjetas-flash-teoria-informatica.pdf
He publicado nuevos apuntes de 1º Análisis Matemático: apuntes-formulas-y-teoria.pdf
He publicado nuevos apuntes de 1º Química: fuerzas-intermoleculares.pdf
He publicado nuevos apuntes de 1º Química: tema-estructura-atomica-y-propiedades-periodicas.pdf
He publicado nuevos ejercicios de 1º Química: Relacion-ejercicios-enlace-y-estructura.pdf